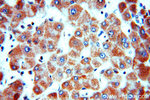
SLC25A20 Antibody in Immunohistochemistry (Paraffin) (IHC (P))

Search
Proteintech
SLC25A20 Polyclonal Antibody
{{$productOrderCtrl.translations['antibody.pdp.commerceCard.promotion.promotions']}}
{{$productOrderCtrl.translations['antibody.pdp.commerceCard.promotion.viewpromo']}}
{{$productOrderCtrl.translations['antibody.pdp.commerceCard.promotion.promocode']}}: {{promo.promoCode}} {{promo.promoTitle}} {{promo.promoDescription}}. {{$productOrderCtrl.translations['antibody.pdp.commerceCard.promotion.learnmore']}}
产品信息
19363-1-AP
种属反应
已发表种属
宿主/亚型
分类
类型
抗原
偶联物
形式
浓度
规格
纯化类型
保存液
内含物
保存条件
运输条件
产品详细信息
Immunogen sequence: GKKLQQKHP EDVLSYPQLF AAGMLSGVFT TGIMTPGERI KCLLQIQASS GESKYTGTLD CAKKLYQEFG IRGIYKGTVL TLMRDVPASG MYFMTYEWLK NIFTPEGKRV SELSA (96-209 aa encoded by B C001689)
靶标信息
SLC25A20 is one of several closely related mitochondrial-membrane carrier proteins that shuttle substrates between cytosol and the intramitochondrial matrix space. It mediates the transport of acylcarnitines into mitochondrial matrix for their oxidation by the mitochondrial fatty acid-oxidation pathway. Mutations in this gene are associated with carnitine-acylcarnitine translocase deficiency, which can cause a variety of pathological conditions such as hypoglycemia, cardiac arrest, hepatomegaly, hepatic dysfunction and muscle weakness, and is usually lethal in new born and infants. This gene product is one of several closely related mitochondrial-membrane carrier proteins that shuttle substrates between cytosol and the intramitochondrial matrix space. This protein mediates the transport of acylcarnitines into mitochondrial matrix for their oxidation by the mitochondrial fatty acid-oxidation pathway. Mutations in this gene are associated with carnitine-acylcarnitine translocase deficiency, which can cause a variety of pathological conditions such as hypoglycemia, cardiac arrest, hepatomegaly, hepatic dysfunction and muscle weakness, and is usually lethal in new born and infants.
仅用于科研。不用于诊断过程。未经明确授权不得转售。
生物信息学
蛋白别名: CAC; Carnitine/acylcarnitine translocase; mitochondrial carnitine-acylcarnitine translocase; Mitochondrial carnitine/acylcarnitine carrier protein; solute carrier family 25 (carnitine/acylcarnitine translocase), member 20; solute carrier family 25 (mitochondrial carnitine/acylcarnitine translocase), member 20; Solute carrier family 25 member 20; unnamed protein product
基因别名: 1110007P09Rik; C78826; CAC; CACT; mCAC; SLC25A20
UniProt ID: (Human) O43772, (Mouse) Q9Z2Z6
Entrez Gene ID: (Human) 788, (Rat) 117035, (Mouse) 57279